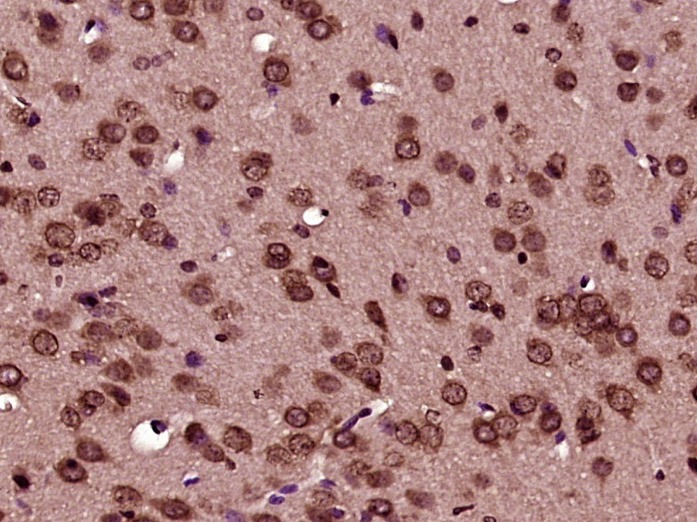

购物车
 您的购物车当前为空
您的购物车当前为空
Anti-BCL-XL Polyclonal Antibody 是一种 Rabbit 抗体,靶向 BCL-XL。Anti-BCL-XL Polyclonal Antibody 可用于 FCM,ICC/IF,IF,IHC-Fr,IHC-P。
别名 PPP1R52, bcl-xS, BCLXS, BCL-XL/S, bcl-xL, BCLXL, Bcl-X, BCLX, BCL2-like 1, BCL2L
Anti-BCL-XL Polyclonal Antibody 是一种 Rabbit 抗体,靶向 BCL-XL。Anti-BCL-XL Polyclonal Antibody 可用于 FCM,ICC/IF,IF,IHC-Fr,IHC-P。
| 规格 | 价格 | 库存 | 数量 |
|---|---|---|---|
| 50 μL | ¥ 1,165 | 5日内发货 | |
| 100 μL | ¥ 1,975 | 5日内发货 | |
| 200 μL | ¥ 2,785 | 5日内发货 |
TargetMol的所有产品仅用作科学研究或药证申报,不能被用于人体,我们不向个人提供产品和服务。请您遵守承诺用途,不得违反法律法规规定用于任何其他用途。
| 产品描述 | Anti-BCL-XL Polyclonal Antibody is a Rabbit antibody targeting BCL-XL. Anti-BCL-XL Polyclonal Antibody can be used in FCM,ICC/IF,IF,IHC-Fr,IHC-P. |
| 别名 | PPP1R52, bcl-xS, BCLXS, BCL-XL/S, bcl-xL, BCLXL, Bcl-X, BCLX, BCL2-like 1, BCL2L |
| Ig Type | IgG |
| 反应种属 | Human,Mouse (predicted:Rat,Dog,Pig,Horse,Sheep) |
| 验证活性 | 1. Paraformaldehyde-fixed, paraffin embedded (mouse brain tissue); Antigen retrieval by boiling in sodium citrate buffer (pH6.0) for 15 min; Block endogenous peroxidase by 3% hydrogen peroxide for 20 min; Blocking buffer (normal goat serum) at 37°C for 30 min; Antibody incubation with (Bcl-xL) Polyclonal Antibody, Unconjugated (TMAB-00202) at 1:400 overnight at 4°C, followed by operating according to SP Kit (Rabbit) instructionsand DAB staining. 2. Paraformaldehyde-fixed, paraffin embedded (mouse testis tissue); Antigen retrieval by boiling in sodium citrate buffer (pH6.0) for 15 min; Block endogenous peroxidase by 3% hydrogen peroxide for 20 min; Blocking buffer (normal goat serum) at 37°C for 30 min; Antibody incubation with (Bcl-xL) Polyclonal Antibody, Unconjugated (TMAB-00202) at 1:400 overnight at 4°C, followed by operating according to SP Kit (Rabbit) instructionsand DAB staining. 3. Blank control: Jurkat. Primary Antibody (green line): Rabbit Anti-Bcl-xL antibody (TMAB-00202) Dilution: 1 μg/Test; Secondary Antibody: Goat anti-rabbit IgG-FITC Dilution: 0.5 μg/Test. Protocol The cells were fixed with 4% PFA (10 min at room temperature) and then permeabilized with 0.1% PBST for 20 min at room temperature. The cells were then incubated in 5% BSA to block non-specific protein-protein interactions for 30 min at room temperature. Cells stained with Primary Antibody for 30 min at room temperature. The secondary antibody used for 40 min at room temperature. 4. Hela cell; 4% Paraformaldehyde-fixed; Triton X-100 at room temperature for 20 min; Blocking buffer (normal goat serum) at 37°C for 20 min; Antibody incubation with (Bcl-xL) polyclonal Antibody, Unconjugated (TMAB-00202) 1:100, 90 minutes at 37°C; followed by a conjugated Goat Anti-Rabbit IgG antibody at 37°C for 90 minutes, DAPI (blue) was used to stain the cell nucleus. 5. Blank control: A431. Primary Antibody (green line): Rabbit Anti-Bcl-xL antibody (TMAB-00202) Dilution: 1 μg/10^6 cells; Isotype Control Antibody (orange line): Rabbit IgG. Secondary Antibody: Goat anti-rabbit IgG-AF647 Dilution: 1 μg/test. Protocol The cells were fixed with 4% PFA (10 min at room temperature) and then permeabilized with 90% ice-cold methanol for 20 min at-20°C. The cells were then incubated in 5% BSA to block non-specific protein-protein interactions for 30 min at at room temperature. Cells stained with Primary Antibody for 30 min at room temperature. The secondary antibody used for 40 min at room temperature. |
| 应用 | FCMICC/IFIFIHC-FrIHC-P |
| 推荐剂量 | IHC-P: 1:100-500; IHC-Fr: 1:100-500; ICC/IF: 1:50-200; IF: 1:100-500; FCM: 1ug/Test |
| 抗体种类 | Polyclonal |
| 宿主来源 | Rabbit |
| 亚细胞定位 | Mitochondrion membrane; Single-pass membrane protein. Nucleus membrane; Single-pass membrane protein; Cytoplasmic side. Cytoplasm, cytoskeleton, centrosome. Note=Mitochondrial membranes and perinuclear envelope. Localizes to the centrosome when phosphorylated at Ser-49. |
| 组织特异性 | Bcl-X(S) is expressed at high levels in cells that undergo a high rate of turnover, such as developing lymphocytes. In contrast, Bcl-X(L) is found in tissues containing long-lived postmitotic cells, such as adult brain. |
| 构建方式 | Polyclonal Antibody |
| 纯化方式 | Protein A purified |
| 性状 | Liquid |
| 缓冲液 | 0.01M TBS (pH7.4) with 1% BSA, 0.02% Proclin300 and 50% Glycerol. |
| 浓度 | 1 mg/mL |
| 研究背景 | The protein encoded by this gene belongs to the BCL-2 protein family. BCL-2 family members form hetero- or homodimers and act as anti- or pro-apoptotic regulators that are involved in a wide variety of cellular activities. The proteins encoded by this gene are located at the outer mitochondrial membrane, and have been shown to regulate outer mitochondrial membrane channel (VDAC) opening. VDAC regulates mitochondrial membrane potential, and thus controls the production of reactive oxygen species and release of cytochrome C by mitochondria, both of which are the potent inducers of cell apoptosis. Two alternatively spliced transcript variants, which encode distinct isoforms, have been reported. The longer isoform acts as an apoptotic inhibitor and the shorter form acts as an apoptotic activator. [provided by RefSeq, Jul 2008]. |
| 免疫原 | KLH conjugated synthetic peptide: human Bcl-xL |
| 抗原种属 | Human |
| 基因名称 | BCL2L1 |
| 基因ID | |
| 蛋白名称 | Bcl-2-like protein 1 |
| Uniprot ID | |
| 研究领域 | Response to hypoxia,Bcl 2 family,Metabolism,Bcl 2 family,Cell survival & death,Oncoproteins,Bcl2 Family,Apoptosis,Hypoxia,Mitochondrial markers,Cancer,Mitochondrial |
| 功能 | Potent inhibitor of cell death. Inhibits activation of caspases (By similarity). Appears to regulate cell death by blocking the voltage-dependent anion channnel (VDAC) by binding to it and preventing the release of the caspase activator, CYC1, from the mitochondrial membrane. Isoform Bcl-X(S) promotes apoptosis. |
| 分子量 | Theoretical: 26 kDa. |
| 储存方式 | Store at -20°C or -80°C for 12 months. Avoid repeated freeze-thaw cycles. |
| 运输方式 | Shipping with blue ice. |